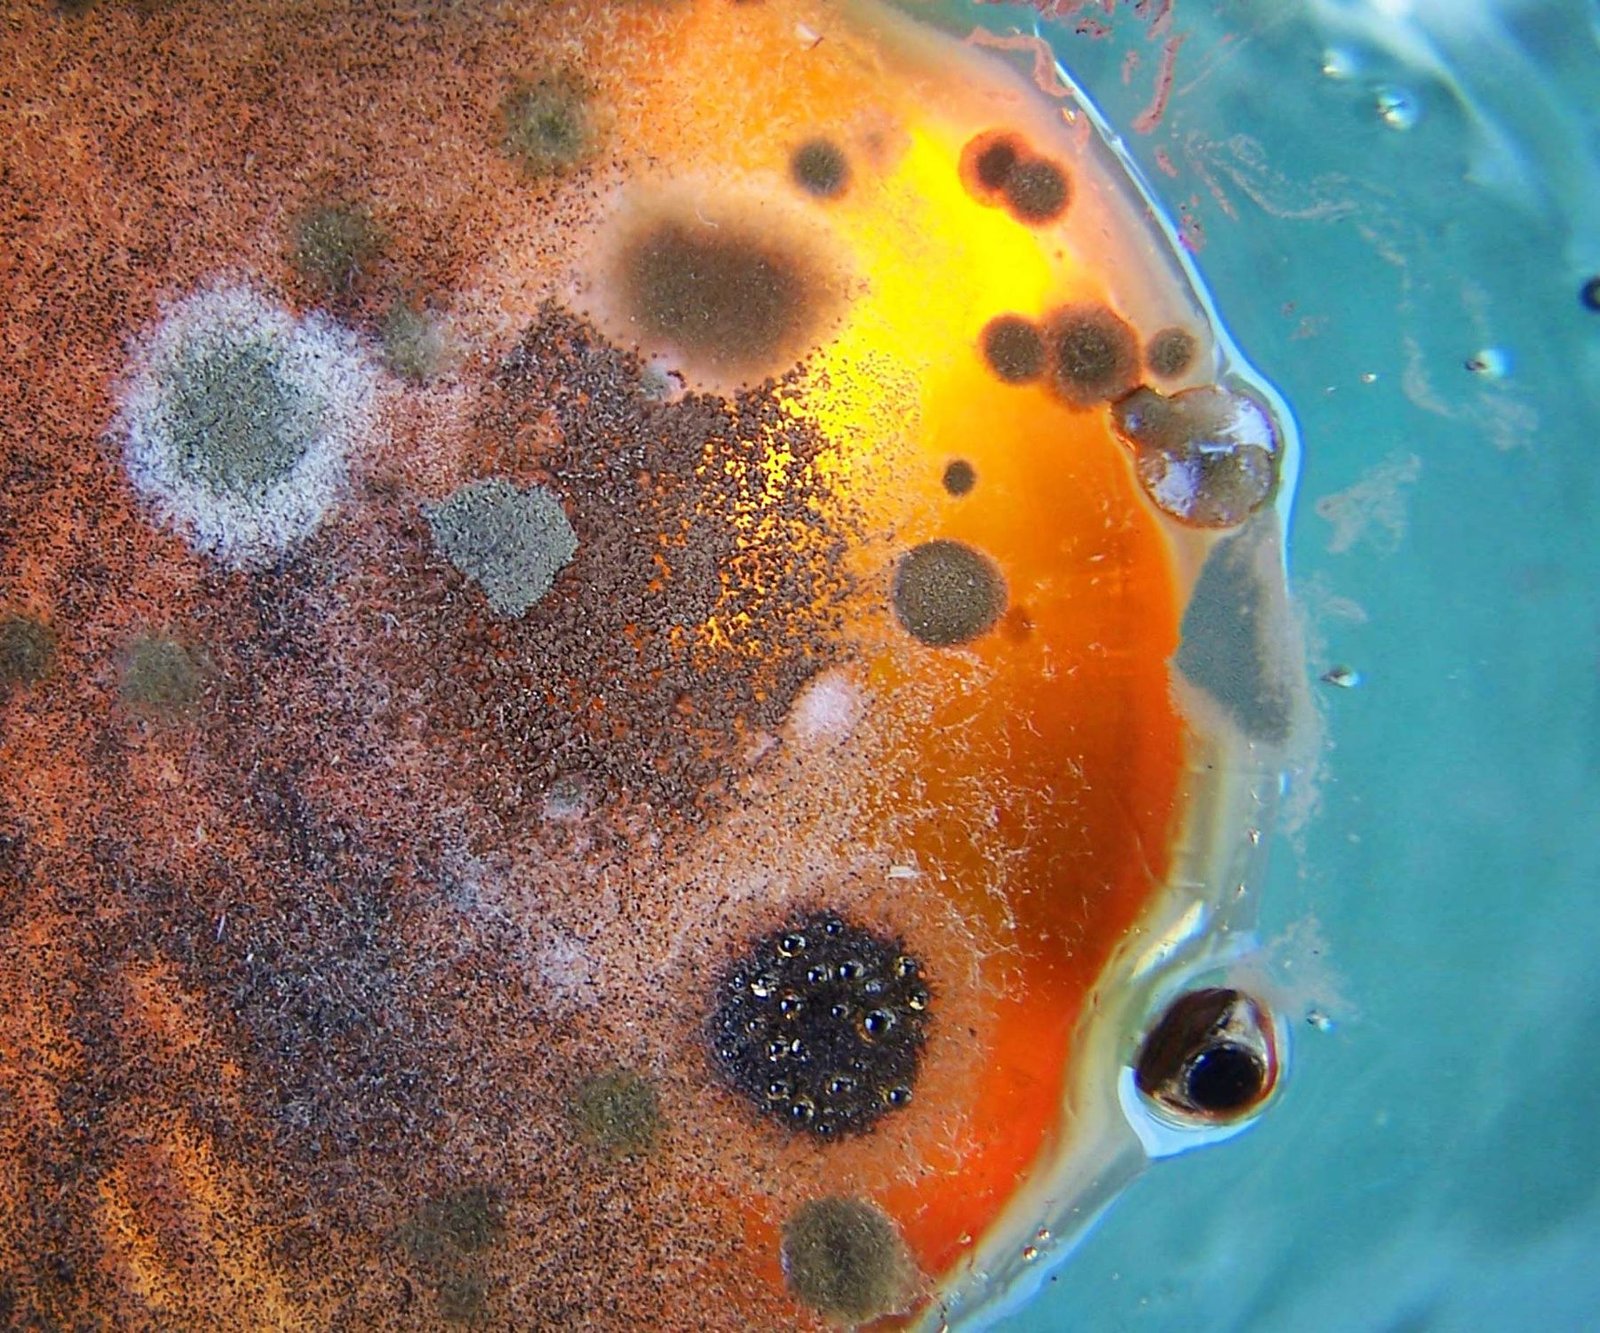

How to Clean Your Window AC Unit: A Step-by-Step Guide
Air Conditioning,All PostsSummer is here and it’s time to get your window AC unit ready for the...

How To Clean Mold From Your Window Air Conditioner- A Step By Step Guide
Air Conditioning,All PostsMold is a common issue that can occur in air conditioners, especially in those that...
How to Clean a Window AC Unit – Without Removing It
Air Conditioning,All PostsHow to Clean a Window AC unit Cleaning a window AC unit can be easy...

How to Clean a Fan (fast and easy)
Fans,All PostsDo you have a fan that you have let go for a little too long...

How to Choose the Right Size Humidifier for Your Room
Humidifiers,All PostsHow to Choose the Right Size Humidifier for Your Room Humidifiers are sized by square...

How to Choose the Right RV Air Conditioner
Air Conditioning,All PostsWhen it comes to enjoying the great outdoors in the comfort of your own RV...

How to Choose The Right Humidifier
All Posts,Humidifiers,Recommended ProductsHumidifiers can be a lifesaver during the winter months when the air is extra dry...

How Often Should You Run An Air Purifier?
Air Purifiers,All PostsHave you recently purchased an air purifier and are wondering where to put it or...

How Often Do You Clean the Filter On a Window AC? – FAQ
Air Conditioning,All PostsWhen the summer heat is pounding down and you need quick relief and don’t want...

Related Posts:
- What Does Ozone Smell Like In An Air Purifier?
- Can Humidifiers Cause Mold?- The Answer May Surprise You
- Hydrogen Peroxide in Humidifier - What's the Controversy?
- Is a Humidifier a Cure for Asthma? (click bait alert)
- Can a Humidifier Make you Sick? (A Better Question is When?)
- What Does a Diffuser Do in a Room?
